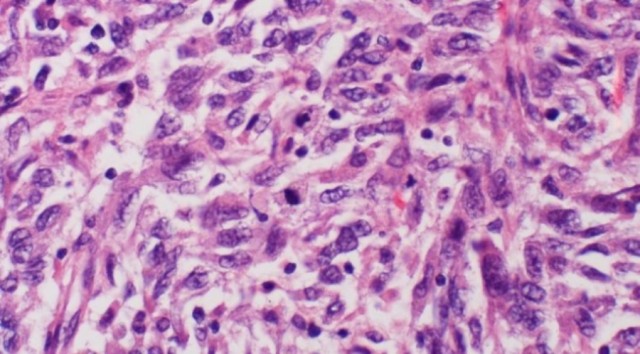

Միչիգանի համալսարանի գիտնականները նոր պատրաստուկ են ստեղծել, որը կարող է կանգնեցնել չարորակ բջիջների աճն ու զարգացումը, որոնք մաշկի ագրեսիվ քաղցկեղ՝ մելանոմա են առաջացնում: Հետազոտության արդյունքները հրապարակվել են Molecular Cancer Therapeutics ամսագրում:
Դեղամիջոցը գործում է չարորակ գոյացություններում ՌՆԹ-ի մոլեկուլներ ստեղծելու օրգանիզմի ունակության հիմքով: Այն 90 տոկոս դեպքերում կասեցնում է քաղցկեղային բջիջների աճը եւ օրգանիզմում դրանց տարածումը, հատկապես հիվանդության վաղ փուլերում:
Գիտնականները հետազոտության ընթացքում թուլացած իմունիտետով մկներին մարդու մելանոմայի բջիջներ են ներարկել, որից հետո նրանց վրա ազդել են սինթետիկ դեղամիջոցով, որը ներգործում է ՌՆԹ-ի մոլեկուլներ եւ ուռուցքի բջիջներին հատուկ որոշակի սպիտակուցներ արտադրելու գեների ունակության վրա: Որպես կանոն, այդ գեները նպաստում են հիվանդության տարածմանը: Դեղամիջոցը ճնշել է մելանոմայի բջիջների աճը:
Նշանակալի է այն փաստը, որ գիտնականները նախապես այս դեղամիջոցը՝ CCG-203971, դիտարկում էին որպես սկլերոդերմիայի դեմ միջոց, որը հազվադեպ եւ հաճախ մահացու աուտոիմունային հիվանդություն է, որը մաշկային ծածկույթի, թոքերի, սրտի, երիկամների եւ այլ օրգանների կարծրացում է առաջացնում:
Հետազոտության համահեղինակ, Միչիգանի համալսարանի դեղագործության եւ թունաբանության ֆակուլտետի դեկան, բժշկական գիտությունների դոկտեր Ռիչարդ Նոյբիգը հայտնել է, որ այս հայտնագործությունը չափազանց խոստումնալից է, քանի որ մելանոմայի մետաստազները կարող են ուղեղը եւ թոքերը ախտահարել նույնիսկ ուռուցքը վիրահատելուց հետո: Նրա խոսքով՝ դրա կանխումը կկարողանա մեծ թվով մարդկանց կյանքը փրկել:
Գոյություն ունի մելանոմայի երկու տարատեսակ՝ մեկը ավելի հաճախ է մետաստազներ ունենում, մյուսը՝ հազվադեպ: Բիոփսիայի միջոցով բժիշկը կարող է որոշել, թե հիվանդի մոտ այդ տեսակներից որն է առկա: Եթե նրա մոտ մելանոման ավելի մեծ հավանականությամբ մետաստազներ կունենա, ապա բժիշկը կարող է նոր դեղամիջոցը նախօրոք ներարկել:
Բայց ի՞նչ անել մյուս 10 տոկոսի համար: Նոյբիգը ուշադրություն է դարձնում այն փաստին, որ փորձը թուլացած իմունիտետով մկների վրա է անցկացվել, որպեսզի մելանոման արագ սերտաճի: «Եթե խոսքը մարդու մասին է, ապա երբ բջիջների 90 տոկոսը վնասազերծված է, իմունային համակարգն ավելի շուտ կհաղթի եւ սկսածը կավարտի»,- նշել է նա:

20:03

15:37

15:04

15:03

15:02

14:48

14:33

14:16

14:04

13:48

13:34

13:15

13:00

12:46

12:37

12:17

12:04

11:45

11:18

09:36
| երկ | երք | չրք | հնգ | ուրբ | շբթ | կրկ | |
| 1 | 2 | 3 | 4 | 5 | |||
| 6 | 7 | 8 | 9 | 10 | 11 | 12 | |
| 13 | 14 | 15 | 16 | 17 | 18 | 19 | |
| 20 | 21 | 22 | 23 | 24 | 25 | 26 | |
| 27 | 28 | 29 | 30 | ||||

09:36

09:19

09:02

09:44

09:18

09:02

09:39

09:18

09:02

09:55

09:42

09:18

09:02

09:34

09:18

09:02

09:38

09:19

09:02

09:52

09:36

09:19

09:02

09:36

09:15

09:02

09:36

09:19

09:13

09:01

09:47

09:35

09:17

09:02

09:33

09:16

09:02

09:48

09:34

09:16

09:02

09:49

09:36

09:15

09:55

09:42

09:33

09:19

09:02

09:44